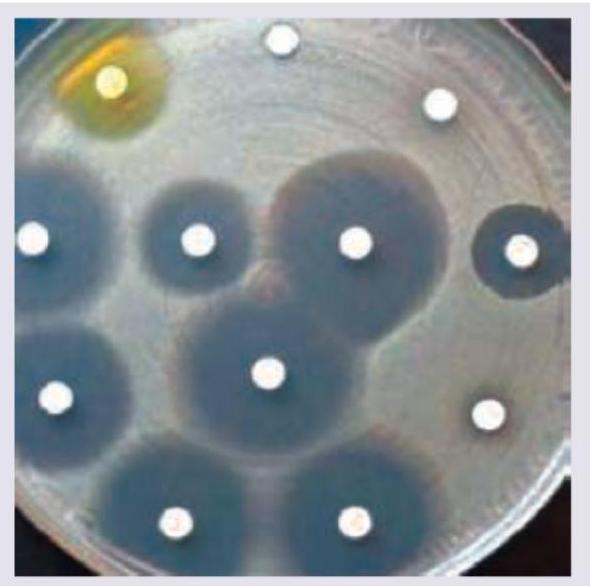
Image for question 51

Enter your email to get your 85% OFF code and unlock the full NEET PG question bank on the app.
Name the test being performed.
A 15-year-old child with rheumatic heart disease is having hoarseness of voice. Mark the nerve involved in the diagram shown below:

An intra-operative photograph of cortical mastoidectomy is shown. Identify the lateral semi-circular canal. (AIIMS Nov 2017)

All are seen in this girl child except:

What investigations and management are indicated in the condition shown in the image?

A child is brought to your OPD with rashes as shown below along with fever. Diagnosis is:

What is the location of Erb's point during auscultation?
A 58-year-old male patient presents with halitosis, mild dysphagia and regurgitation of previous day food. Barium study is performed. Where is the location of this presentation?

Which of the statements regarding Calot's triangle are correct? 1. Common hepatic duct forms the medial boundary of the Calot's triangle 2. Inferior surface of the right lobe of the liver forms the superior boundary of Calot's triangle 3. Right hepatic artery is usually found as a content of the Calot's triangle 4. Cystic duct and medial border of gall bladder forms the lateral border of Calot's triangle Select the correct answer using the code given below:
Ptosis in Horner syndrome is due to paralysis of which muscle?
Anatomical Basis of Common Clinical Conditions
Practice Questions
Surgical Anatomy
Practice Questions
Anatomical Basis of Trauma
Practice Questions
Anatomical Aspects of Infections
Practice Questions
Anatomical Considerations in Regional Anesthesia
Practice Questions
Anatomical Basis of Physical Examination
Practice Questions
Clinical Correlations in Neuroanatomy
Practice Questions
Anatomical Approaches in Minimally Invasive Procedures
Practice Questions
Imaging Correlations in Clinical Anatomy
Practice Questions
Anatomical Variations of Clinical Importance
Practice Questions
Get full access to all questions, explanations, and performance tracking.
Scan to download app